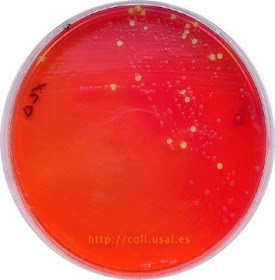
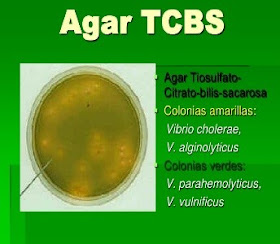

Agar Cetrimida Sin Inocular

Preparacion De Medios De Cultivo Microbiologicos Docsity

Cetrimide Agar Pseudomonas Aeruginosa Isolation Sigma Aldrich

Cetrimide Selective Agar Preparation Microdok Microbiology
Q Tbn And9gcrt9peup6jsyflqdfuywnivtqr8ld6jdqjhynze3 Rpb14jwsh Usqp Cau
Http Repositorio Unap Edu Pe Bitstream Handle Unap Sandra Beatriz Butron Pinazo Pdf Sequence 1 Isallowed Y

N Acil Homoserina Lactonas Producidas Por Pseudomonas Aeruginosa Como Promotoras Del Crecimiento Radicular De Solanum Lycopersicum L
Estas sales de amonio se van a desdoblar en amoniaco produciendo la consiguiente alcalinidad El medio utilizado es el Agar Citrato de Simmons" que lleva como indicador el azul de bromotimol (cuando el pH es alcalino vira a azul intenso, mientras que el medio sin inocular tiene un color verde) Técnica Se utiliza un tubo inclinado.

Agar cetrimida sin inocular. Cetrimida 03 g Agar 136 g Glicerina 10 mL Agua purificada 1000 mL pH final 72 ± 02 Resultado de medio sin inocular sin cambio LIMITACIONES Ocasionalmente, algunas cepas de Klebsiella, Enterobacter, Citrobacter, Proteus, Providencia, Alcaligenes y Aeromonas pueden. Inocula ĭnok´ulum (pl inoc´ula ) ( L ) material used in inoculation. 1 Inocular una porción anormal de heces (con moco, sangre o pus) o de muestra similar, directamente en una caja de MacConkey y una caja de SS El inóculo se coloca con asa en anillo (flameada y fría) o con hisopo en las cajas de ambos medios Inocular sólo 1/2 cm en un extremo en el MacConkey y 1 cm en el SS.
Academiaedu is a platform for academics to share research papers. Cienc Tecnol Aliment 5(2) (06) ISSN ©06 SOMENTA 136 líquido antes de ser inoculadas en salchichas, encontrando que la supervivencia de estas bacterias se incrementó probablemente debido a la exposición prolongada al calor. 5) Como control de esterilidad, adicionar a placas petri, agar sin inocular y agar inoculado con el diluyente 6) Una vez solidificado el agar, invertir las placas e incubarlas a 29°– 31° c C durante 48 / 3 horas.
Población afectada deberá recibir sin demora las recomendaciones oportunas Artículo 4 Obligaciones generales 1 Sin perjuicio de sus obligaciones con arreglo a otras normas comunitarias, los Estados miembros Cetrimida, Agar (Placa Preparada (Ø 55 mm) y filtro) CULTIMED. 1 Inocular una porción anormal de heces (con moco, sangre o pus) o de muestra similar, directamente en una caja de MacConkey y una caja de SS El inóculo se coloca con asa en anillo (flameada y fría) o con hisopo en las cajas de ambos medios Inocular sólo 1/2 cm en un extremo en el MacConkey y 1 cm en el SS. Por 10 tanto, debe titularse cada lote.
Cetrimida Agar Uso Medio utilizado para el aislamiento selectivo de Pseudomonas aeru ginosa y de otras especies del género Su fórmula cumple con los requerimientos de la Armonización de Farmacopeas Europea, Japonesa y de los Estados Unidos de Nor teamérica (EP, JP y USP respectivamente). 7445 Prueba de reducción de nitratos a nitritos Inocular en 5 mL de caldo nitrato con la suspensión del cultivo, utilizando asa de 3 mm Incubar por 24 horas a 35° C ± 2° C 7446 Agar MYP puede ser omitido si los resultados son determinantes en las placas de agar. Inocular en caldo Mossel el material homogenizado, diluir (1, 01 y 001 g/ml), sembrar en Agar bilis violeta con glucosa/lactosa Incubar a 35°C por 14 h Estimar recuento de colonias bien desarrolladas color rojizo (Gramnegativo).
Incubar a 30 a 35 durante 18 a 24 horasSelección y subcultivosubcultivo en una placa de agar cetrimida, y se incuba a 30 a 35 durante 18 a 72 horasInterpretaciónCrecimiento de colonias indica la posible presencia de P aeruginosa Esto es confirmado por las pruebas de identificación. Sin inocular Color verde a azul verdoso PROCEDIMIENTO Materiales suministrados BD TCBS Agar (placas Stacker de 90 mm) Controladas microbiológicamente Material no suministrado Medios de cultivo auxiliar, reactivos y el equipo de laboratorio que se requiera Tipos y transporte de las muestras. Agar is the solidifying agent Starch acts as a colloid that protects against toxic material in the media El crecimiento en caldo de cultivo se observa por la presencia de turbidez en comparación con un control sin inocular Nota Algunos factores pueden afectar a los resultados cantidad de inóculo, tasa de crecimiento,.
De inoculación inocular el medio de cultivo, picando el fondo y extendiendo sobre la superficie del mismo en agar MacConkey y en medios simples con o sin agregado de NaCl, Cetrimida (antisepsia de la piel sana) Derivados de biguanidas y amidinas. Cetrimida agar foundation, förberedelse, användningar den cetrimidagar eller cetrimid är ett selektivt fast odlingsmedium, utformat för isolering av Pseudomonas aeruginosa Det bygger på att lyfta fram pigmentproduktionen som är karakteristisk för denna art och utvecklades från modifieringen av Tech agar, skapad av King, Ward och Raney. TABLA DE CONTENIDO 1 Objetivo 2 Introducci贸n 3 Bioseguridad 4 Control de calidad 5 Agar Nutritivo 6 Agar Sangre 7 Agar Mc Conkey 8 Agar Muller Hinton 9.
Los medios deshidratados se utilizan para una gran variedad de aplicaciones, tienen ventajas importantes con respecto a los medios en polvo convencionales Son de alta calidad y cumplen los estándares de control en alimentos, análisis microbiológicos de productos finales y materias primas y control de calidad de la industria farmacéutica y cosmética. Características Pseudomonas spp su morfología colonial es característica de identificación en algunos medios de cultivo, por ejemplo en medio agar Cetrimida, es un bacilo curvo o recto, aislado o en pareja o cadenas cortas, Gram negativa () esta bacteria tiene motilidad positiva gracias a su flagelo (solo cuenta con uno) Tiene la capacidad de formar biofilm, tiene un ligero aroma a. BD Pseudosel Agar (agar cetrimida) se utiliza para el aislamiento selectivo de Pseudomonas aeruginosa a partir de muestras clínicas Sin inocular Ambar pálido PROCEDIMIENTO Materiales suministrados BD Pseudosel Agar (placas Stacker de 90 mm) Controladas microbiológicamente.
Agar de Nitrato (“Nitrate Agar”) Determinar si la bacteria tiene la capacidad de reducir los nitratos a nitritos Estriado en agar inclinado 2448 hrs / 37°C 1 gota de ácido sulfanílico 1 gota de αnaphtilamina En caso que dé negativo, se añade una pizca de polvo de zinc Rojo al añadir los primeros dos reactivos El medio se queda. Desarrollo bacteriano y, si lo hubiera, inocular con un ansa la superficie de Agar Vogel Johnson (o Agar BairdParker o Agar ManitolSal) y de Agar Cetrimida Tapar, invertir las placas e incubar Si ninguna de las placas contiene colonias con lás características descriptas en la Tabla 2 y en la Tabla 3 para los medios. PROVEEDORES de BASE AGAR CETRIMIDA, COMPRADORES, Información Comercial, Precios de BASE AGAR CETRIMIDA, Información Técnica, Noticias, Imágenes, Artículos.
Por favor, visite vwrcompara laactualizacióndeprecios, certificados, SDS ynuevosproductos Descripción Relleno. Composición de cetrimida Agar Ingredientes En gm / litro Pancreático Recopilación de gelatina ,0 g Sulfato de Potasio 10,0 g Cloruro de magnesio 1,4 g Bromuro de cetiltrimetilamonio 03 gm Glicerol 10,0 ml Agar 13,6 g Agua destilada 1000 ml El pH final de 7,2 / 0,2 a 25 grados C Principio de cetrimida Agar Cetrimida Agar se. Inocular 0,1 ml del cultivo overnight de Escherichia coli en uno de los tubos caldo LB A este tubo lo llamaremos “cultivo experimental” Dejar el otro tubo sin inocular marcado como “blanco” Colocar el tubo blanco en el espectrofotómetro Llevar absorbancia a “cero” Retirarlo.
Agar cetrimida agar selectivo para Pseudomonas (base) para microbiología (According harm EP/USP/JP) Find MSDS or SDS, a COA, data sheets and more information. Composición de cetrimida Agar Ingredientes En gm / litro Pancreático Recopilación de gelatina ,0 g Sulfato de Potasio 10,0 g Cloruro de magnesio 1,4 g Bromuro de cetiltrimetilamonio 03 gm Glicerol 10,0 ml Agar 13,6 g Agua destilada 1000 ml El pH final de 7,2 / 0,2 a 25 grados C Principio de cetrimida Agar Cetrimida Agar se. 31 Agar Cetrimida Agar King Uso Medio de cultivo selectivo para el aislamiento de Pseudomonas aeruginosa a partir de diversas muestras Principio La cetrimida (Bromuro de cetiltrimetilamonio) inhibe el crecimiento de las bacterias debido a su acción como un compuesto cuaternario de amonio.
Colonias incoloras, sin halos negros Sin inocular Ámbar claro, tono marrón verdoso muy claro PROCEDIMIENTO Materiales suministrados BD Enterococcosel Agar (placas Stacker de 90 mm) Controladas microbiológicamente Material no suministrado. Gelatina Sin embargo, y a sugerencia de una ayudante, introdujo el agar Tiene alguna ventaja el uno sobre el otro?. Inhibición de parcial a completa;.
Cetrimida Agar es un medio selectivo y diferencial utilizado para el aislamiento e identificación de Pseudomonas aeruginosa partir de muestras clínicas y no clínicas Cetrimida es el agente selectivo e inhibe la mayoría de las bacterias al actuar como un detergente (bromuro de cetiltrimetilamonio, un amonio cuaternario, detergente catiónico). Pues la ventaja fundamental de usar un medio de cultivo líquido, es que permite que crezcan bacterias que se encuentran en muy poca cantidad, es decir, cuya concentración es muy baja en la muestra que estemos analizando. El Agar Cetrimida es un medio selectivo para el aislamiento y recuento de Pseudomonas aeruginosa en productos biológicos, farmacéuticos y cosméticosLa composición se basa en la Farmacopea de los Estados Unidos.
1 Definir y preparar el medio de cultivo (Cetrimida Agar Base) 2 Medio liquido (en tubos de ensayo Autoclave 121° por 15 min) 3 Medio Sólidos Medio liquido agaragar 4 Inocular la cepa ACTIVACION 1 Seguir las instrucciones según la casa comercial (Frasco con la cepa Frasco de fluido de hidratación) 2. Agar cetrimida agar selectivo para Pseudomonas (base) para microbiología (According harm EP/USP/JP) Find MSDS or SDS, a COA, data sheets and more information. Sin embar go, la base de estas Agar tripticasa soyalecit inapolisorbato 80 (TWEEN 80) Agar ManitolSal Agar BairdParker Agar VogelJohnson Agar Cetrimida Agar Pseudomonas para la detección de fluoresceína Agar Pseudomonas para la detección de Piocianina Caldo Lactosado Caldo selenito cistina.
0,2 *Ajustada y/o suplementada para satisfacer los criterios de rendimiento. Se caracterizan por ser redondas, lisas, brillantes y ligeramente aplanadas medio para aumentar la selectividad;. Medio sin inocular sin cambios cetrimida agar base laboratorios britania sa los patos 2175 (c12abi) caba argentina tel/fax 54 11 4306 0041 11 /1 5 rev 0 1 sÍmbolos utilizados diagnÓstico in vitro cÓdigo nº elaborador estÉril nº de determinaciÓnes lote nº fecha de vencimiento lÍmite de temperatura instrucciones de uso hoja 2 de 2.
Cetrimida agar foundation, forberedelse, anvendelser den cetrimidagar eller cetrimid er et selektivt fast dyrkningsmedium, designet til isolering af Pseudomonas aeruginosa Det er baseret på at fremhæve produktionen af pigmenter, der er karakteristiske for denne art, og blev udviklet fra modifikationen af Tech agar, skabt af King, Ward og Raney. Cetrimide or Cetrimide Agar is a selective solid culture medium designed for the isolation of Pseudomonas aeruginosa It is based on showing the production of characteristic pigments of this species and was made from the modification of Tech agar, created by King, Ward and Raney. O Scribd é o maior site social de leitura e publicação do mundo.
CETRIMIDE AGAR (BASE) PHARMACOPEA MEDIO N Aislamiento selectivo para Pseudomonas aeruginosa en medicamentos (USP) y cosméticos (ISO ) COMPOSICIÓN Peptona pancreátgelatina ,0 g Cetrimida 0,3 g Cloruro magnésico 1,4 g Sulfato Dipotásico 10,0 g Agaragar 13,6 g (Fórmula por litro) pH final 7,2 ± 0,2. Sin embargo aportan a los microorganismos un sustrato idóneo para su crecimiento y consiste en inocular los cosméticos en un medio El medio agar cetrimida para la detección de Ps. Composición de cetrimida Agar Ingredientes En gm / litro Pancreático Recopilación de gelatina ,0 g Sulfato de Potasio 10,0 g Cloruro de magnesio 1,4 g Bromuro de cetiltrimetilamonio 03 gm Glicerol 10,0 ml Agar 13,6 g Agua destilada 1000 ml El pH final de 7,2 / 0,2 a 25 grados C Principio de cetrimida Agar Cetrimida Agar se.
Cetrimida agar foundation, persiapan, penggunaan itu agar setrimid atau cetrimide adalah media kultur padat selektif, yang dirancang untuk isolasi Pseudomonas aeruginosa Itu didasarkan pada menyoroti produksi karakteristik pigmen dari spesies ini dan dikembangkan dari modifikasi agar Tech, yang dibuat oleh King, Ward dan Raney. AGAR MACCONKEY Medio de cultivo sólido Las colonias sospechosas de Shigella no fermentan a la lactosa Son incoloras y transparentes Otros microorganismos que fermentan a la lactosa (coliformes) son colonias rosas o rojizas( Ejem. Cetrimida agar foundation, förberedelse, användningar den cetrimidagar eller cetrimid är ett selektivt fast odlingsmedium, utformat för isolering av Pseudomonas aeruginosa Det bygger på att lyfta fram pigmentproduktionen som är karakteristisk för denna art och utvecklades från modifieringen av Tech agar, skapad av King, Ward och Raney.
Sin zona clara Agar cetrimida Medio para Pseudomonas Selectivo, parcialmente dif i l Contiene Peptona diferencial Cloruro de magnesio Sulfato de potasio Cetrimida (detergente catiónico P aeruginosa en agar cetrimida (detergente catiónico, bromuro de cetiltrimetil amonio) Adición de ácido nalidíxico Producción de pigmentos pioverdina. Agaragar 35 pH final 73 02 de observar Procedimiento Tomar una colonia a inocular e introducir el asa recta en el tubo (en el centro) hasta aproximadamente 2/3 de la profundidad del medio El medio se incuba a 35 °C 14 horas y se observa para. Aislamiento de Vibrio cholerae a partir de muestros fecales Figura IV·1 Las colonias de V cholerae cu~ivadas en agar TeBS durante 1 B a 24 horas son grandes (2 a 4 mm) y amarillas debido a la fermenlaci6n de Ia sacarosa;.
Agar Bismuto Sulfito presentación Caja unidades, placas de 90 mm Catálogo 926(Medio preparado) Listo para su uso PRINCIPIOS Y APLICACION AGAR BISMUTO SULFITO es una modificación de eutilizado para la detección de l Medio Wilson Blair, Salmonella, en particular Salmonella typhi de muestras clínicas. Los científicos utilizan por lo general gelatina o agar en platos petri para estudiar los cultivos bacterianos, pero la gelatina sin sabor gelatina es un buen sustituto que se puede usar en casa La gelatina, derivada del colágeno de la piel y de los huesos de animales, proporciona un medio para que puedan crecer diferentes tipos de bacterias. Academiaedu is a platform for academics to share research papers.
El agar cetrimida o cetrimide es un medio de cultivo sólido selectivo, diseñado para el aislamiento de Pseudomonas aeruginosa Está basado en poner en evidencia la producción de pigmentos característicos de esta especie y fue elaborado a partir de la modificación del agar Tech, creado por King, Ward y Raney. PROVEEDORES de BASE AGAR CETRIMIDA, COMPRADORES, Información Comercial, Precios de BASE AGAR CETRIMIDA, Información Técnica, Noticias, Imágenes, Artículos. Agaragar 10,5 g Cromógeno termoestable cs (Fórmula por litro) pH final 7,0 ± 0,2 recuentos sin PREPARACIÓN Disolver 19 g de medio en 1 litro de agua destilada Calentar hasta ebullición, agitando para su completa disolución Repartir en tubos o frascos Autoclavar a 121 ºC durante 15 min o preferiblemente a 116°C durante 15 minutos.
Agar cetrimida LI según EP 30 ml Application Isolation of Pseudomonas aeruginosa in nonsterile pharmaceutical products Packaging 90 mm settle plate with 30 ml filling volume ( or 1 plates per box) for long incubation (LI) Synonym Pseudomonas Selective Agar Find MSDS or SDS, a COA, data sheets and more information. Identi˚car la muestra a sembrar, inocular el medio de cultivo por agotamiento utilizando asa calibrada de 10 ul, incubar en aerobiosis, a 3537 º C durante 18 a 24 horas, para microorganismos de fácil crecimiento, para bacterias de crecimiento exigente y de Streptococcus de cualquier grupo en atmósfera con 5 % de CO2, a. Precoz sin tener COMPOSICIÓN Peptona pancreática de gelatina ,0 g Cetrimida 0,3 g Cloruro magnésico 1,4 g Sulfato Dipotásico 10,0 g Agaragar 13,6 g Mezcla cromogénica en frasco cs (Fórmula por litro) pH final 7,2 ± 0,2 PREPARACIÓN Disolver 44,5 g de medio en 1 litro de agua destilada.
Características Pseudomonas spp su morfología colonial es característica de identificación en algunos medios de cultivo, por ejemplo en medio agar Cetrimida, es un bacilo curvo o recto, aislado o en pareja o cadenas cortas, Gram negativa () esta bacteria tiene motilidad positiva gracias a su flagelo (solo cuenta con uno) Tiene la capacidad de formar biofilm, tiene un ligero aroma a. Se utilizaron 2 testigos medio de cultivo sin inocular y el cultivo del hongo inactivado por esterilización, ambos con las mismas concentraciones de paraquat a las que se expuso cada cepa Todas las muestras fueron filtradas (filtros Whatman, grado 6) y centrifugadas (5000 rpm durante 10 min) a 4 °C. Por favor, visite vwrcompara laactualizacióndeprecios, certificados, SDS ynuevosproductos Descripción Relleno.
SABOURAUD CHLORAMPHENICOL GENTAMICIN ACTIDIONE AGAR Candida tropicalis ATCC 750 2448 horas a 3035°C Sin crecimiento Candida glabrata, Cryptococcus neoformans y hongos como Aspergillus, se recomienda inocular en paralelo un medio sin actidiona 10 BIBLIOGRAFÍA 1 Pharmacopée Européenne Addendum 42 de la 4e édition 02.
Www Seimc Org Contenidos Documentoscientificos Procedimientosmicrobiologia Seimc Procedimientomicrobiologia28 Pdf
Http Mdmcientifica Com Wp Content Uploads 16 12 Cetrimide Medio Agar Mdm Cient C3 Adfica Inserto O P Pd 63 Pdf
Cfgsmicrobiologia Files Wordpress Com 17 01 4 Control Microbiologico De Aguas Scharlab Pdf

30 Ideas De Medios De Cultivo Y Microorganismos En 21 Medio De Cultivo Microorganismos Microbiologia

Shigella

Cetrimide Agar Pseudomonas Aeruginosa Isolation Sigma Aldrich
Http Www Clinicord Com Wp Content Uploads Descargas Manual Oxoid Pdf

Perfil Profesional Bacteriologia

Mannitol Salt Agar

Apuntes Laboratorio Micro Ubb Studocu

Medios
El Maravilloso Mundo De La Microbiologia Clinica Pruebas Bioquimicas En Area De La Microbiologia Clinica

Agar Cetrimida Agar King Microbiologia Bienestar

Pseudomonas Aeruginosa Principal Responsable De La Retirada De Cosmeticos

30 Ideas De Medios De Cultivo Y Microorganismos En 21 Medio De Cultivo Microorganismos Microbiologia

Analisis Fisico Quimico Y Bacteriologico De Aguas El Sindical
1

Creative Commons Atribucion Nocomercial Sinderivadas 2 5 Peru Pdf Free Download

Pseudomonas Agar P Laboratorios Britania
Http Www Red Gdl Com Wp Content Uploads 14 06 Catalogo Bioxon Pdf

Cetrimide Agar Pseudomonas Aeruginosa Isolation Sigma Aldrich

Manual Microbiologia 03 By Laboratorio De Microbioloxia E Biotecnoloxia Issuu

Resource Pseudomonas Aeruginosa Pseudomonas

Agar Cetrimida Fundamento Preparacion Usos

Amazon Com Cetrimide Select Agar 10 Por Paquete Industrial Scientific

Pseudomonas Microbiologia

Informacion Y Novedades Sobre Medios De Cultivo
Silo Tips Download Medios De Cultivo Preparados
Www Revistaespacios Com A18v39n13 A18v39n13p14 Pdf
Http Www Fbioyf Unr Edu Ar Rrii Varios Pdf10sharapin Sharapin10 Caceres Controlcalidad Pdf

Agar Pseudomonas Pseudomonas Aeruginosa

Medios De Cultivo Archives Pagina 23 De 47 Microkit Medios De Cultivo
Http Www Adiveter Com Ftp Public Articulo790 Pdf

Infoleg Ministerio De Justicia Y Derechos Humanos Argentina

Introduccion A La Horac C Facultad A Micr Cio A Lo Coordinado De Ciencia Robiolo Pardo Or S Exact By Mery Lizarraga Morales Issuu

Cetrimide Agar Culture Media Microbe Notes

Cetrimide Agar 90mm Plate Southern Group Laboratory
El Maravilloso Mundo De La Microbiologia Clinica Pruebas Bioquimicas En Area De La Microbiologia Clinica

𝘚𝘢𝘭𝘮𝘰𝘯𝘦𝘭𝘭𝘢 𝘵𝘺𝘱𝘩𝘪 Atcc En Agar Sulfito De Bismuto Catalogo 1026 Microbiologia Medio De Cultivo Bismuto
Http Www Losproductosdealdo Com Inc Pdf Cat Cultimed Pdf

Informacion Y Novedades Sobre Medios De Cultivo
Http Repositorio Lamolina Edu Pe Bitstream Handle Unalm 18 P34 F4 T Pdf Sequence 1 Isallowed Y

Microbiologia General Instituto De Investigaciones Biotecnologicas Id 5c4e102d02d6d

Medios

Control De Calidad Microbiana De Inoculantes Ppt Descargar

Cetrimide Select Agar 10 Por Paquete Industrial Scientific Amazon Com
2

Agar Macconkey Medio De Cultivo Solido Ppt Video Online Descargar

Preparacion De Medios De Cultivo Microbiologicos Docsity
Dspace Unl Edu Ec Jspui Bitstream 4154 1 Le C3 93n benavides tannya katheryne Pdf
Www Seimc Org Contenidos Documentoscientificos Procedimientosmicrobiologia Seimc Procedimientomicrobiologia28 Pdf

Microbiologia General Pdf Free Download

30 Ideas De Medios De Cultivo Y Microorganismos En 21 Medio De Cultivo Microorganismos Microbiologia

Medios De Cultivo En Un Laboratorio De Microbiologc3ada

Agar Macconkey Medio De Cultivo Solido Ppt Video Online Descargar

Agar Cetrimida Fundamento Preparacion Usos
Http Www Ictsl Net Downloads Microbiologia Pdf

Sharapin10 Caceres Controlcalidad Pdf Control De Calidad Microbiologica De Plantas Medicinales Y Productos Fitofarmaceuticos Armando C U00e1ceres Course Hero
Edoc Pub Download Tipos De Agar Pdf Free Html
Http Www Adiveter Com Ftp Public Articulo790 Pdf

Ppt Agar Macconkey Medio De Cultivo Solido Powerpoint Presentation Free Download Id
Http Repositorio Unp Edu Pe Bitstream Handle Unp 2158 Bio Pin Cam 19 Pdf Sequence 1 Isallowed Y
Http Www Digemid Minsa Gob Pe Upload Uploaded Pdf Establecimientos Reuniones Reunion Ii Ii Ensayos Microbiol C3 gicos En Control De Calidad Pdf

Cetrimide Agar Composition Principle Uses Preparation And Colony Morphology

Cetrimide Selective Agar For Pseudomonas Aeruginosa

Agar Manitol Salado Acido Compuestos Quimicos

Ppt Agar Macconkey Medio De Cultivo Solido Powerpoint Presentation Free Download Id

Microbiologia General Pdf Free Download

El Maravilloso Mundo De La Microbiologia Clinica Pruebas Bioquimicas En Area De La Microbiologia Clinica
2
Www Microkit Es Pdf Catalogo Microkit 15 Pdf
Edoc Pub Download Tipos De Agar Pdf Free Html

Unidad 2 Microbiologia By Jazina Ruiz Hernandez Issuu

3 Prueba Del Agar Hierro

Cetrimide Agar Pseudomonas Aeruginosa Isolation Sigma Aldrich
Www Com Resource Aspx Idx 59

Doc Analisis Microbiologico De Productos No Esteriles Pruebas Para Microorganismos Especificos Rocio Soto Academia Edu

Informacion Y Novedades Sobre Medios De Cultivo

Apuntes Laboratorio Micro Ubb Studocu

Cultivos Ficha Tecnica Para Medios Solidos Calameo Downloader
Q Tbn And9gcrgjt16x 3h2n9e8zrofxhr52iubn03qpmlldxwnbxd9 H Ti3u Usqp Cau

Pdf Diseno Docente Para La Realizacion De Practicas De Control De La Calidad Microbiologica De Productos Cosmeticos Y De Dermofarmacia
Q Tbn And9gctefycdhnynioi7kgipkpln0ovqbzk1mxi04brg4hvwk5xyhs7g Usqp Cau
Http Repositorio Sibdi Ucr Ac Cr 8080 Jspui Bitstream 1 Pdf

Microbiologia General Guia De Trabajos Practicos
Http Www Dspace Uce Edu Ec Bitstream 3 T Uce 0008 Cqu 042 Pdf

Pdf Biorremediacion De Lodos Contaminados Con Aceites Lubricantes Usados
Www Microkit Es Pdf Catalogo Microkit 15 Pdf

Pseudomonas Aeruginosa Principal Responsable De La Retirada De Cosmeticos

Agar Macconkey Medio De Cultivo Solido Ppt Video Online Descargar

Pdf Pag 54 Marco Normativo Para Registro Y Control De Inoculantes Formulados Con Microorganismos Promotores Del Crecimiento Vegetal En Uruguay Maria Del Carmen Mayans Academia Edu
Www Condalab Com Int En Index Php Controller Attachment Id Attachment 107

90

Aeruginosa P Putida P Fluorescens Morfologia

Cetrimide Agar Base

Mannitol Salt Agar

Tecnicas De Inoculacion Y Sangria De Animales Doc Document
2



